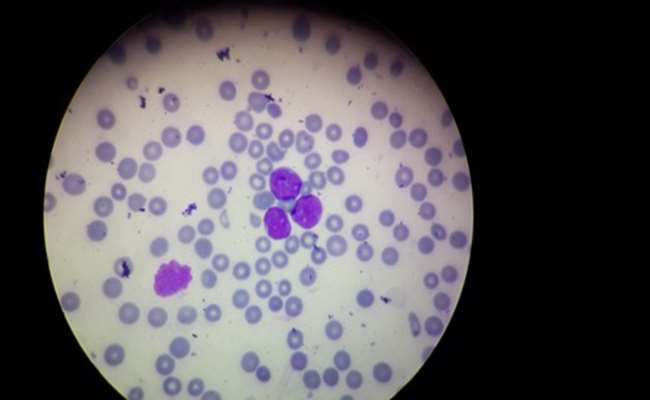
گالری تصاویر

آخرین اخبار
سامانه های مرکز تحقیقات سلول های بنیادی
تصاویر و رسانه مرکز
تصاویر و رسانه مرکز تحقیقات سلول های بنیادی خونساز
دستاورد های مرکز تحقیقات سلول های بنیادی خونساز

سمینار ها
در این قسمت میتوانید سمینار های برگزار شده توسط مرکز تحقیقات سلول های بنیادی خونساز را مشاهده فرمایید.

سمپوزیوم ها

کتب تالیف شده

مقالات پژوهشی
در این قسمت میتوانید لیست مقالات برتر چاپ شده در ژورنال ها و سایت های علمی برتر دنیا را مطالعه فرمایید.
آخرین اخبار از دستاوردها
همه رویداد ها

معرفی کتابهای منتشرشده مرکز تحقیقات سلولهای بنیادی خونساز
.png)
محققان مرکز تحقیقات سلولهای بنیادی خونساز، مکانیسم اثر سلول های بنیادی خونساز در ترمیم زخم را بررسی کردند.
پیوند سلولهای بنیادی خونساز چیست و چگونه به درمان بیماران کمک میکند؟

ارتباط میان رژیمهای غذایی التهابی و خطر ابتلا به مولتیپل میلوما — نتایج یک مطالعه مورد-شاهدی جدید
سلولدرمانی گامی بسوی بهبود پاسخ به درمان و کاهش عوارض
.png)






.png)

.png)


.png)
.png)
.png)

.png)

.png)